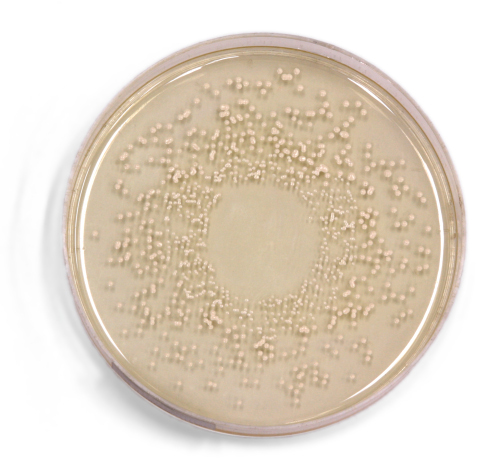

Questo il risultato di uno studio realizzato da ricercatori della University of Alabama a Birmingham e del Southern Research Institute, pubblicata online sulla rivista Federation of American Societies for Experimental Biology.
I casi di influenza più gravi son quelli nei quali i liquidi si accumulano nei polmoni rendendo difficile la respirazione, impedendo all’ossigeno di entrare in circolazione nel sangue.
I ricercatori riferiscono che una proteina prodotta dal virus, M2, danneggia la proteina che nei polmoni si occupa di equilibrare la presenza di liquidi ne polmoni, liberando radicali liberi e ossidanti.
Questi ultimi sono importanti perchè svolgono un ruolo determinante nel distruggere gli agenti patogeni che attaccano le cellule, ma il loro sviluppo incontrollato può essere tossico.
Gli scienziati, adottando tecniche di biologia molecolare, hanno iniettato in uova di rana la proteina incriminata insieme alle proteine che nel polmone si occupano della rimozione dei fluidi, e sono riusciti ad isolare il segmento proteico responsabile del danno.
Riducendo il segmento della proteina, questa non era più in grado di attaccare la proteina presente nei polmoni.
Un secondo esperimento sempre su uova di rana ha ottenuto un risultato analogo quando nelle uova di rana è stato iniettata la proteina del virus e la sua proteina bersaglio insieme con antiossidanti.
Anche in questo caso, la proteina virale non era più in grado di danneggiare la proteina del polmone.
Ripetendo lo stesso esperimento su cellule umane i ricercatori hanno ottenuto analoghi risultati.
Tale scoperta potrebbe essere particolarmente utile, sostengono i ricercatori, non solo per capire il modo in cui l’influenza attacca i polmoni ma anche per individuare nuove strategie terapeutiche e medicinali che rendano innocua la proteina incriminata.
Những sản phẩm cá cược thể thao luôn được thiết kế với 4 phong cách khác nhau như OW – Sự đa dạng, TP – Tượng trưng cho hiện đại, SB – Sự truyền thống, KS – Trải nghiệm. Bảng tỷ lệ kèo 888SLOT chính thức luôn cập nhật mới mỗi ngày để tiện cho anh em chủ động tham khảo, tỷ lệ thưởng luôn hấp dẫn, tối ưu cơ hội chiến thắng cho thành viên tham gia. TONY06-22